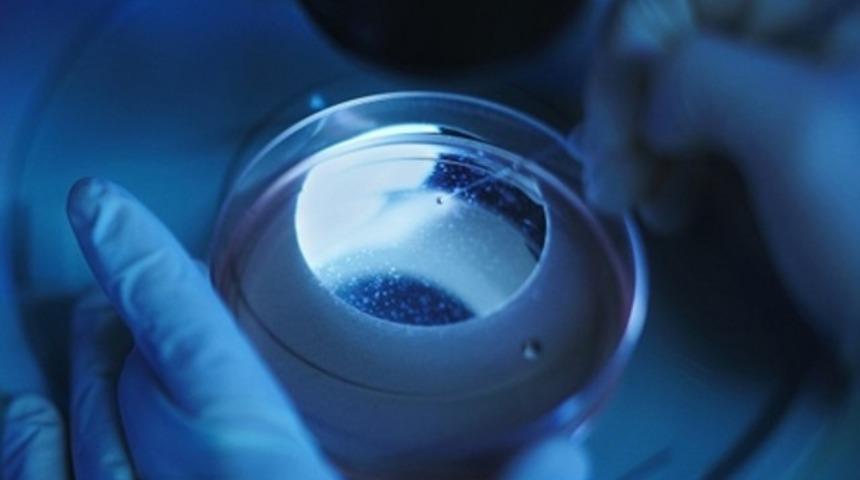
Kısırlık yakın zamanda sona erecek

Nature dergisine göre, bu uygulama ilerleyen zamanlarda yumurta gerekmeden insan üremesinde de kullanılabilecek.
Bu uygulama, yakın zamanda araştırmacılar tarafından gerçekleştirilen kök hücrelerden oluşturulan büyüyen kalp dokusuna benzerlik gösteriyor.
Katsuhiko Hayashi ve ekibi daha önce, dişi fare kuyruğunun derisinden alınan hücreleri kök hücrelerine dönüştürerek 2007 yılında nobel ödülü kazanmışlardı.
Kök hücreler daha sonra Hayashi’nin 2012 yılında geliştirdiği bir işlem kullanılarak cinsiyet hücrelerine dönüştürüldü.
Son olarak, olgun olmayan cinsiyet hücreleri, fare yumurta hücreleri ile birlikte bir petri çanağı içine yerleştirildi. Amaç bu hücrelerin canlı yavru üretmek için döllenmiş olgun yumurta hücreleri olduklarını sanmalarını sağlamaktı.
Hayashi’nin ekibi ayrıca, erkek fare kuyruğu hücrelerinden de yumurta hücreleri oluşturmayı başardı. Bu olay, ilerleyen zamanlarda iki biyolojik babaya sahip olunabileceği anlamına geliyor.
Bu uygulama teorik olarak insan kök hücreleriyle de uygulanabilir ama etik ve yüksek başarısızlık oranları sebebiyle yakın zamanda gerçekleşemeyeceği aşikar. Ancak o zamana kadar Hayashi ve ekibi için sonraki adım, primatlar üzerinde araştırma yapmaları olacak.